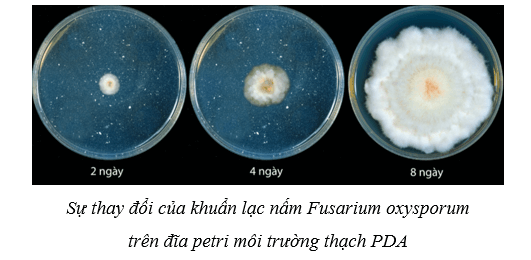
Lý thuyết Sinh học 10 Cánh diều Bài 18: Sinh trưởng và sinh sản ở vi sinh vật

Lý thuyết Sinh học 10 Cánh diều bài 18
Lý thuyết Sinh học lớp 10 bài 18: Sinh trưởng và sinh sản ở vi sinh vật được VnDoc sưu tầm và tổng hợp các câu hỏi lí thuyết và trắc nghiệm có đáp án đi kèm nằm trong chương trình giảng dạy môn Sinh học lớp 10 sách Cánh diều.
Bài: Sinh trưởng và sinh sản ở vi sinh vật
A. Lý thuyết Sinh học 10 bài 18
I. Sinh trưởng của vi sinh vật
1. Khái niệm về sinh trưởng của vi sinh vật
- Sự sinh trưởng, phát triển của vi sinh vật thường được mô tả bằng sự sinh trưởng của một quần thể vi sinh vật do vi sinh vật có kích thước rất nhỏ, thường không quan sát được sự sinh trưởng và phát triển của từng cá thể bằng mắt thường.
- Khái niệm sinh trưởng của vi sinh vật: Sinh trưởng của vi sinh vật là sự tăng lên về số lượng tế bào của quần thể vi sinh vật thông qua quá trình sinh sản.

2. Các pha sinh trưởng của quần thể vi khuẩn
- Trong hệ kín (môi trường mà các chất dinh dưỡng không được bổ sung thêm đồng thời không rút bớt sản phẩm và chất thải trong suốt quá trình nuôi), sự sinh trưởng của quần thể vi khuẩn được diễn ra theo 4 pha:

|
Đặc điểm |
Pha tiềm phát (pha lag) |
Pha lũy thừa (pha log) |
Pha cân bằng |
Pha suy vong |
|
Quần thể vi khuẩn |
- Vi khuẩn thích ứng dần với môi trường, chúng tổng hợp các enzyme trao đổi chất và DNA, chuẩn bị cho quá trình phân bào. - Mật độ tế bào vi khuẩn trong quần thể gần như không thay đổi. |
- Vi khuẩn phân chia mạnh mẽ. - Mật độ tế bào vi khuẩn trong quần thể tăng nhanh, quần thể đạt tốc độ sinh trưởng tối đa. |
- Số tế bào sinh ra cân bằng với số tế bào chết đi. - Mật độ tế bào vi khuẩn trong quần thể hầu như không thay đổi. |
- Số tế bào chết hoặc bị phân hủy nhiều hơn số tế bào sinh ra. - Mật độ tế bào vi khuẩn trong quần thể bắt đầu suy giảm. |
|
Dinh dưỡng |
- Dinh dưỡng đầy đủ cho sự sinh trưởng của quần thể vi khuẩn. |
- Dinh dưỡng đầy đủ nhưng tiêu hao nhanh cho sự sinh trưởng của quần thể vi khuẩn. |
- Dinh dưỡng bắt đầu thiếu hụt cho sự sinh trưởng của quần thể vi khuẩn. |
- Dinh dưỡng cạn kiệt và các chất độc hại cho sự sinh trưởng của quần thể vi khuẩn tích lũy tăng dần. |
- Biện pháp để khắc phục hiện tượng mật độ tế bào vi khuẩn không tăng ở pha cân bằng là: Bổ sung thêm chất dinh dưỡng và lấy bớt đi dịch nuôi cấy.
II. Sinh sản của vi sinh vật
1. Sinh sản ở vi sinh vật nhân sơ
1.1. Phân đôi
- Phân đôi là hình thức sinh sản của phần lớn các vi sinh vật nhân sơ và là hình thức phân bào không có thoi vô sắc (trực phân).

- Cơ chế phân đôi của vi khuẩn:
+ Nhiễm sắc thể mạch vòng của chúng bám vào cấu trúc gấp nếp trên màng sinh chất (gọi là mesosome) làm điểm tựa để nhân đôi và phân chia về hai tế bào con. + Tế bào kéo dài, thành và màng tế bào chất thắt lại, hình thành vách ngăn để phân chia tế bào chất và chất nhân về hai tế bào mới.

1.2. Nảy chồi
- Nảy chồi là kiểu sinh sản vô tính có ở một số vi khuẩn, ví dụ như vi khuẩn màu tía Rhodomicrobium vannielli.
- Cơ chế nảy chồi: Màng tế bào phát triển về một phía hình thành ống rỗng → Chất di truyền nhân đôi → Một phần tế bào chất và chất di truyền chuyển dịch vào phần cuối của ống rỗng làm phình to ống rỗng, hình thành chồi, tạo nên tế bào con.

1.3. Hình thành bào tử
- Xạ khuẩn (nhóm vi khuẩn Gram (+) đặc biệt có tế bào dạng sợi) có hình thức sinh sản bằng bào tử vô tính.
- Cơ chế hình thành bào tử vô tính:
+ Phân cắt ở đầu các sợi khí sinh (sợi phát triển trong không khí) để hình thành chuỗi bào tử.
+ Các bào tử có thể đứt ra, phân tán trong môi trường. Khi gặp điều kiện thuận lợi, chúng nảy mầm và phát triển thành cơ thể mới.

2. Sinh sản ở vi sinh vật nhân thực
Vi sinh vật nhân thực có hình thức sinh sản vô tính (nảy chồi, phân đôi hoặc hình thành bào tử vô tính) và sinh sản hữu tính (hình thành bào tử túi, bào tử tiếp hợp,…).
2.1. Phân đôi và nảy chồi
- Phân đôi và nảy chồi là hình thức sinh sản vô tính của vi sinh vật nhân thực. Chúng thực hiện theo kiểu phân bào có thoi vô sắc.

* Điểm khác nhau giữa nảy chồi của nấm men so với nảy chồi ở vi khuẩn:
- Ở nấm men, các chồi mọc lên trực tiếp không có các ống rỗng như nảy chồi ở vi khuẩn.
- Sự phân chia vật chất di truyền trong nảy chồi ở nấm men theo kiểu phân bào có thoi vô sắc còn ở vi khuẩn phân bào không có thoi vô sắc.
2.2. Sinh sản bằng bào tử vô tính
- Hình thành bào tử vô tính là kiểu sinh sản vô tính của nhiều nấm sợi.
- Bào tử vô tính được hình thành từ các sợi nấm sinh dưỡng, không có sự kết hợp của các giao tử đực và cái:
+ Các nấm mốc thuộc chi Aspergillus và chi Penicillium hình thành bào tử đính dạng hở trên sợi khí sinh.
+ Nấm mốc chi Mucor hình thành bào tử đính dạng kín trên sợi khí sinh.

2.3. Sinh sản bằng bào tử hữu tính
- Sinh sản hữu tính có sự kết hợp của các bào tử khác giới chỉ xảy ra ở các vi sinh vật nhân thực, có hình thức phân bào giảm phân.
- Một số hình thức sinh sản hữu tính bằng bào tử thường thấy là: bào tử túi, bào tử đảm, bào tử tiếp hợp và bào tử động (còn gọi là bào tử noãn).


III. Các yếu tố ảnh hưởng đến sinh trưởng của vi sinh vật
1. Các yếu tố hóa học
1.1. Nguồn dinh dưỡng
- Nguồn cung cấp: Tế bào của hầu hết các vi sinh vật hấp thu dinh dưỡng từ môi trường.
- Vai trò: Dinh dưỡng và các chất hóa học trong môi trường có ảnh hưởng trực tiếp đến sinh trưởng của vi sinh vật. Thiếu hụt dinh dưỡng dẫn đến vi sinh vật sinh trưởng chậm hoặc ngừng sinh trưởng.

- Phân loại:
+ Các nguyên tố đại lượng (C, H, O, N, S, P, Na, K, Ca,…) là nguồn dinh dưỡng chủ yếu giúp vi sinh vật tổng hợp nên các chất tham gia cấu tạo và các hoạt động sống của tế bào.
+ Các nguyên tố vi lượng (Fe, Zn, Cu,…) được vi sinh vật sử dụng với lượng nhỏ, chúng là thành phần quan trọng của nhiều enzyme, các vitamin,…
1.2. Các chất hóa học khác
- Độ pH:
+ Mỗi vi sinh vật chỉ có thể sinh trưởng trong khoảng pH thích hợp. Đa số vi khuẩn và nguyên sinh vật phát triển tốt trong môi trường trung tính; nhiều loại nấm sinh trưởng tốt trong môi trường acid; một số nhóm vi sinh vật sống trong các hồ nước mặn có độ pH cao.

+ Cơ chế ảnh hưởng: Độ pH ảnh hưởng đến tính thấm qua màng, hoạt động chuyển hoá vật chất trong tế bào, hoạt tính enzyme,...
+ Ứng dụng: Tạo môi trường pH phù hợp cho các vi sinh vật có lợi phát triển tối ưu. Tạo môi trường pH bất lợi nhằm ức chế vi sinh vật gây hại cho con người.
- Chất ức chế sinh trưởng của vi sinh vật:
+ Gồm một số chất như kim loại nặng, các hợp chất phenol, các chất oxi hóa mạnh, alcohol,…

+ Cơ chế ảnh hưởng: Các chất này có thể gây biến tính và làm bất hoạt protein, phá hủy cấu trúc màng sinh chất,…
+ Ứng dụng: Một số chất này thường được dùng để diệt khuẩn trong y tế và đời sống.

2. Các yếu tố vật lí
2.1. Nhiệt độ
- Mỗi vi sinh vật có thể sinh trưởng được trong dải nhiệt độ thích hợp. Dựa vào khả năng chịu nhiệt, vi sinh vật được chia thành 4 nhóm: ưa lạnh (< 15oC), ưa ấm (20oC – 40oC), ưa nhiệt (55oC – 65oC), ưa siêu nhiệt (85oC – 110oC).

- Cơ chế ảnh hưởng: Nhiệt độ ảnh hưởng đến tốc độ phản ứng sinh hóa học trong tế bào.
- Ứng dụng: Tạo nhiệt độ phù hợp cho vi sinh vật có lợi phát triển tối đa. Tăng nhiệt độ để tiêu diệt hoặc hạ nhiệt độ để ức chế sự sinh trưởng của vi sinh vật gây hại.
2.2. Áp suất thẩm thấu
- Hầu hết các vi sinh vật thích ứng sinh trưởng ở điều kiện áp suất thường. Trong khi đó, các nhóm vi sinh vật ưa áp suất cao, ưa áp suất thấp,… được tìm thấy ở các điều kiện sống có áp suất khác nhau (ví dụ dưới đáy biển sâu hay trên núi cao).
- Cơ chế ảnh hưởng: Khi đưa vi sinh vật vào môi trường ưu trương, nước trong cơ thể vi sinh vật bị rút ra ngoài, gây co nguyên sinh làm chúng không thể phân chia được.
- Ứng dụng: Tạo môi trường ưu trương để gây co nguyên sinh nhằm ức chế sự sinh trưởng của vi sinh vật gây hại.
2.3. Độ ẩm
- Phần lớn vi sinh vật thích ứng sinh trưởng ở độ ẩm trên 90 %. Một số ít các vi sinh vật như xạ khuẩn, nấm sợi có khả năng sinh trưởng ở độ ẩm thấp dưới 90 %.
- Cơ chế ảnh hưởng: Vi sinh vật rất cần nước vì ảnh hưởng đến sự hòa tan các chất dinh dưỡng, thủy phân cơ chất,... Nếu không có nước, vi sinh vật sẽ ngừng sinh trưởng và hầu hết sẽ chết.
- Ứng dụng: Tạo độ ẩm phù hợp cho các vi sinh vật có lợi phát triển tối ưu. Tạo độ ẩm bất lợi (phơi khô) nhằm ức chế các vi sinh vật gây hại cho con người.

3. Các yếu tố sinh học
- Yếu tố sinh học là các yếu tố do sinh vật sản sinh ra gây ảnh hưởng đến các sinh vật khác sống trong cùng môi trường.
- Một số yếu tố sinh học ảnh hưởng đến sinh trưởng của vi sinh vật:
+ Một số sinh vật có khả năng sinh các chất kích thích các nhóm vi sinh vật khác nhau sinh trưởng. Ví dụ: Một số thực vật tiết các chất hữu cơ đặc thù qua rễ, kích thích sự phát triển của khu hệ vi sinh vật vùng rễ.

+ Nhiều nhóm vi sinh vật có khả năng sinh các chất ức chế như kháng sinh, bacteriocin,… để ức chế sinh trưởng của các vi sinh vật xung quanh.
4. Thuốc kháng sinh
- Thuốc kháng sinh là chế phẩm có khả năng tiêu diệt hoặc ức chế đặc hiệu sự sinh trưởng của một hoặc một vài nhóm vi sinh vật.
- Ứng dụng:
+ Thuốc kháng sinh được dùng điều trị các bệnh nhiễm trùng ở người, động vật và thực vật.
+ Việc lạm dụng kháng sinh gây hiện tượng nhờn thuốc nhanh chóng ở nhiều vi sinh vật gây bệnh, làm cho việc tiếp tục sử dụng kháng sinh đó để điều trị bệnh không còn hiệu quả.
B. Bài tập trắc nghiệm Sinh học 10 bài 18
Câu 1: Sự sinh trưởng của quần thể vi khuẩn được nuôi trong môi trường mà các chất dinh dưỡng không được bổ sung thêm đồng thời không rút bớt sản phẩm và chất thải trong suốt quá trình nuôi diễn ra theo
A. 4 pha.
B. 2 pha.
C. 3 pha.
D. 1 pha.
Đáp án: A
Giải thích: Sự sinh trưởng của quần thể vi khuẩn được nuôi trong môi trường mà các chất dinh dưỡng không được bổ sung thêm đồng thời không rút bớt sản phẩm và chất thải trong suốt quá trình nuôi diễn ra theo 4 pha: pha tiềm phát, pha lũy thừa, pha cân bằng, pha suy vong.
Câu 2: Trình tự các pha sinh trưởng của quần thể vi khuẩn trong môi trường nuôi cấy không liên tục là
A. pha tiềm phát → pha lũy thừa → pha cân bằng → pha suy vong.
B. pha tiềm phát → pha cân bằng → pha luỹ thừa → pha suy vong.
C. pha lũy thừa → pha tiềm phát → pha suy vong → pha cân bằng.
D. pha lũy thừa → pha tiềm phát → pha cân bằng → pha suy vong.
Đáp án: A
Giải thích: Trình tự các pha sinh trưởng của quần thể vi khuẩn trong môi trường nuôi cấy không liên tục là: pha tiềm phát → pha lũy thừa → pha cân bằng → pha suy vong.
Câu 3: Pha tiềm phát không có đặc điểm đặc điểm nào sau đây?
A. Dinh dưỡng đầy đủ cho sự sinh trưởng của quần thể vi khuẩn.
B. Vi khuẩn thích ứng dần với môi trường và tổng hợp các enzyme trao đổi chất.
C. Các chất độc hại cho sự sinh trưởng của quần thể vi khuẩn tích lũy nhiều.
D. Mật độ tế bào vi khuẩn trong quần thể chưa tăng (gần như không thay đổi).
Đáp án: C
Giải thích: Trong pha tiềm phát, các chất độc hại cho sự sinh trưởng của quần thể vi khuẩn chưa tích lũy.
Câu 4: Sinh trưởng của vi sinh vật là
A. sự tăng lên về số lượng tế bào của quần thể vi sinh vật thông qua quá trình sinh sản.
B. sự tăng lên về số lượng tế bào của quần thể vi sinh vật thông qua quá trình nguyên phân.
C. sự tăng lên về số lượng tế bào của cơ thể vi sinh vật thông qua quá trình sinh sản.
D. sự tăng lên về số lượng tế bào của cơ thể vi sinh vật thông qua quá trình nguyên phân.
Đáp án: A
Giải thích: Sinh trưởng của vi sinh vật là sự tăng lên về số lượng tế bào của quần thể vi sinh vật thông qua quá trình sinh sản.
Câu 5: Trong nuôi cấy không liên tục, để thu được lượng sinh khối của vi khuẩn tối đa nên tiến hành thu hoạch vào thời điểm nào sau đây?
A. Đầu pha lũy thừa.
B. Cuối pha lũy thừa.
C. Đầu pha tiềm phát.
D. Cuối pha cân bằng.
Đáp án: B
Giải thích: Trong nuôi cấy không liên tục, để thu được lượng sinh khối của vi khuẩn tối đa nên tiến hành thu hoạch vào thời điểm cuối pha lũy thừa vì lúc này sinh khối là lớn nhất và số lượng vi khuẩn chết chưa nhiều.
Câu 6: Mật độ tế bào vi khuẩn trong quần thể bắt đầu suy giảm ở
A. pha tiềm phát.
B. pha lũy thừa.
C. pha cân bằng.
D. pha suy vong.
Đáp án: D
Giải thích: Mật độ tế bào vi khuẩn trong quần thể bắt đầu suy giảm ở pha suy vong.
Câu 7: Để khắc phục hiện tượng mật độ tế bào vi khuẩn không tăng ở pha cân bằng có thể thực hiện biện pháp nào sau đây?
A. Bổ sung thêm một lượng vi sinh vật giống thích hợp.
B. Bổ sung thêm nguồn chất dinh dưỡng vào môi trường.
C. Bổ sung thêm khí oxygen với nồng độ thích hợp.
D. Bổ sung thêm khí nitrogen với nồng độ thích hợp.
Đáp án: B
Giải thích: Một trong những nguyên nhân khiến cho mật độ tế bào vi khuẩn trong quần thể hầu như không tăng ở pha cân bằng là do chất dinh dưỡng bắt đầu thiếu hụt cho sự sinh trưởng của quần thể vi khuẩn → Để khắc phục hiện tượng mật độ tế bào vi khuẩn không tăng ở pha cân bằng có thể thực hiện biện pháp là bổ sung thêm nguồn chất dinh dưỡng vào môi trường.
Câu 8: Cho các hoạt động sau:
(1) Nhiễm sắc thể mạch vòng của chúng bám vào cấu trúc gấp nếp trên màng sinh chất để làm điểm tựa.
(2) Nhiễm sắc thể mạch vòng nhân đôi.
(3) Tế bào kéo dài, thành và màng tế bào chất thắt lại để hình thành vách ngăn phân chia tế bào chất và chất nhân về hai tế bào mới.
Trình tự các hoạt động trong quá trình phân đôi ở vi sinh vật nhân sơ là
A. 1 → 2 → 3.
B. 1 → 3 → 2.
C. 2 → 3 → 1.
D. 2 → 1 → 3.
Đáp án: A
Giải thích: Diễn biến của quá trình phân đôi ở vi sinh vật nhân sơ là: Nhiễm sắc thể mạch vòng của chúng bám vào cấu trúc gấp nếp trên màng sinh chất để làm điểm tựa → Nhiễm sắc thể mạch vòng nhân đôi → Tế bào kéo dài, thành và màng tế bào chất thắt lại để hình thành vách ngăn phân chia tế bào chất và chất nhân về hai tế bào mới.
Câu 9: Cho các hình thức sinh sản sau:
(1) Phân đôi
(2) Nảy chồi
(3) Hình thành bào tử vô tính
(4) Hình thành bào tử tiếp hợp
Số hình thức sinh sản có cả ở vi sinh vật nhân sơ và vi sinh vật nhân thực là
A. 1.
B. 2.
C. 3.
D. 4.
Đáp án: C
Giải thích:
- Các hình thức sinh sản có cả ở vi sinh vật nhân sơ và vi sinh vật nhân thực là: phân đôi, nảy chồi, hình thành bào tử.
- Hình thức sinh sản bằng bào tử tiếp hợp chỉ có ở vi sinh vật nhân thực.
Câu 10: Thiếu hụt chất dinh dưỡng sẽ khiến vi sinh vật
A. sinh trưởng chậm hoặc ngừng sinh trưởng.
B. sinh trưởng và sinh sản nhanh chóng hơn.
C. tăng cường quang hợp để tự tổng hợp chất dinh dưỡng.
D. tăng cường hô hấp kị khí để tự tổng hợp chất dinh dưỡng.
Đáp án: A
Giải thích: Các chất dinh dưỡng có ảnh hưởng trực tiếp đến sinh trưởng của vi sinh vật → Thiếu hụt dinh dưỡng dẫn đến vi sinh vật sinh trưởng chậm hoặc ngừng sinh trưởng.
>>>> Bài tiếp theo: Lý thuyết Sinh học 10 Cánh diều bài 19
Như vậy VnDoc đã giới thiệu các bạn tài liệu Lý thuyết Sinh học lớp 10 bài 18: Sinh trưởng và sinh sản ở vi sinh vật sách Cánh diều. Mời các bạn tham khảo thêm tài liệu: Trắc nghiệm Sinh học 10, Giải bài tập Sinh học lớp 10, Giải Vở BT Sinh Học 10, Sinh học 10 Kết nối tri thức, Sinh học 10 Chân trời sáng tạo, Tài liệu học tập lớp 10.